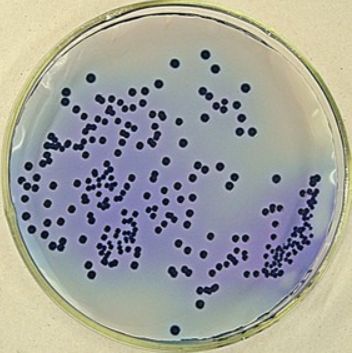
产品封面图

万千商家帮你免费找货
0 人在求购买到急需产品
- 详细信息
- 文献和实验
- 技术资料
- 库存:
100
- 英文名:
Trichoderma virens
- 保质期:
详见说明书
- 供应商:
上海晅科生物科技有限公司
- 保存条件:
2-8℃
- 规格:
冻干粉/菌液
菌种名称:绿木霉
拉丁学名:Trichoderma virens
提供形式:冻干粉;平板
储存条件:培养物和冻干菌种应在 2~8℃保存,勿长期置于室温。
有效期:6 年
活化步骤: ①准备上述平板 1-2 块;②安瓿管表面消毒后在安全柜中打开, 用酒精灯灼烧顶部,后迅速滴上无菌水使之破裂,随后用镊子 将其敲碎;③吸取 0.5mL 无菌水(置于厌氧环境平衡 24h)打入冻干管,充分溶解菌粉后,打入平板中 200μL/个,涂布均匀; ④将平板置于上述培养条件下培养,7-10 天。

绿木霉注意事项:
1、请务必了解培养微生物需要注意的安全事项,默认由微生物专业技术人员操作;
2、建议严格按照 培养说明来操作,认真阅读说明,尤其是要点提示部分,并记录好菌种编号和菌种制作日期(批号);
3、使用前,认真阅读并理解随货的“菌种培养说明”和“开管说明”如有任何疑问,请于操作前咨询我司。
4、如若有菌种复苏不活或污染等情况,请在收到菌种后1个月内联系我司,逾期将不予受理。
菌种保藏是指保持微生物菌株的活力和遗传性状的技术。微生物在使用和传代过程中容易发生污染、变异甚至死亡,因而常常造成菌种的衰退。菌种保藏的目的就是使菌株存活、不丢失、不污染杂菌、不发生或少发生变异,保持菌种原有的活性和各种特征。菌种保藏的基本原理是使微生物的生命活动处于半永久性的休眠状态,也就是将微生物的新陈代谢作用限制在最低范围内。
实验室常用的保菌方法有:甘油保菌法、斜面保菌法、穿刺保菌法、液体石蜡覆盖保藏法、沙土保藏法、冷冻干燥法。微基生物在以上几种菌种保藏方法的基础上,开发出了保菌效果更好瓷珠保菌法。

| 惰性乳杆菌 | Lactobacillus iners Falsen et al. 1999 | 冻干粉;平板 |
| 詹氏乳酸杆菌 | Lactobacillus jensenii Gasser et al. 1970 | 冻干粉;菌液;平板 |
| 氧化葡萄糖酸杆菌 | Gluconobacter oxydans | 冻干粉;斜面;菌液;平板 |
| 变形杆菌定量菌株 | Proteus sp. | 西林瓶;(5.7±0.7)×10^8CFU/瓶 |
| 古氏副拟杆菌 | Parabacteroides goldsteinii | 冻干粉;菌液;平板 |
| 冷解糖芽孢杆菌 | Peribacillus psychrosaccharolyticus | 冻干粉;斜面;菌液;平板 |
| 嗜冷芽孢八叠球菌 | Sporosarcina psychrophila | 冻干粉;斜面;菌液;平板 |
| 麦格伦拟杆菌.麦格理尼斯亚种 | Paenibacillus macquariensis subsp. macquariensis | 冻干粉;斜面;菌液;平板 |
| 凝结芽孢杆菌 | Bacillus coagulans | 冻干粉;斜面;菌液;平板 |
| 新型隐球酵母 | Cryptococcus neoformans | 冻干粉;斜面;菌液;平板 |
| 栖稻假单胞菌 | Pseudomonas oryzihabitans | 冻干粉;斜面;菌液;平板 |
| 单核增生李斯特菌 | Listeria monocytogenes | 冻干粉;平板 |
| 烟曲霉 | Aspergillus fumigatus | 冻干粉;斜面;菌液;平板 |
| 烟曲霉 | Aspergillus fumigatus | 冻干粉;斜面;平板 |
| 黄曲霉 | Aspergillus flavus | 冻干粉;斜面;菌液;平板 |
| Apibacter raozihei | Apibacter raozihei | 冻干粉;斜面;菌液;平板 |
风险提示:丁香通仅作为第三方平台,为商家信息发布提供平台空间。用户咨询产品时请注意保护个人信息及财产安全,合理判断,谨慎选购商品,商家和用户对交易行为负责。对于医疗器械类产品,请先查证核实企业经营资质和医疗器械产品注册证情况。
文献和实验为植物病毒病的一种病征症。即在茎梢或叶细胞内有病毒繁殖时,叶绿体发育不良,或叶绿素减少,由此而引起黄化或白化,使病叶或新生叶变成黄-黄绿色,此现象称为失绿。在部分发生这种情况时,就出现mosaic病征,而变成病斑。
雁形目鸭科河鸭属的 1种。又名小凫,八鸭,小蚬鸭。繁殖于欧亚大陆北部;迁徙时遍及中国东北、华北全境;越冬区很广阔,自河北省起,南至海南省,西达新疆维吾尔自治区和西藏自治区南部。 绿翅鸭有 3亚种,在中国境内的是指名亚种(A.c.crecca)。体形小,体重约250克,翅长200毫米以下,雌雄异色。雄鸟头颈暗栗色,头侧有1条辉绿色带斑自眼周延至后颈,带斑上下缘有棕白色狭纹;下颈、肩及两胁灰黑并密布白色虫蠹状细纹;翼镜金绿色,外缘绒黑;下体棕白,胸部缀有黑色斑点,颏及尾
无脊椎动物,腔肠动物门,珊瑚虫纲,海葵目。为与珊瑚的亲缘关系较近的单体动物,但体内无骨骼。体呈圆柱状,高 3~ 5毫米,用下端的基盘附着在岩石、贝壳或海蟹的甲壳上;上端为绿色的口盘,中央为长裂缝状的口,口的周围有多数绿色触手排成数轮,触手数通常为 6的倍数,当充分伸展时,呈菊花状,受刺激可迅速缩入体内。体壁呈暗绿色,表面有很多纵行的疣突,在近口盘处的疣突较为粗大。体壁上有小孔,体内的毒丝可由小孔伸出孔外。身体受刺激也可以收缩。雌雄异体。为我国黄海和东海中常见的一种